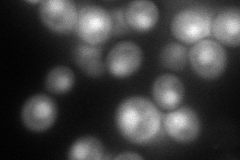
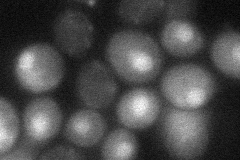

View description
Catalytic subunit of the Hat1p-Hat2p histone acetyltransferase complex that uses the cofactor acetyl coenzyme A, to acetylate free nuclear and cytoplasmic histone H4; involved in telomeric silencing and DNA double-strand break repair
Localization:
Intensity:
Fold change:
Significance:
-
C’ GFP library in SD

cytosol22.18 -
N' NOP1pr-GFP in SD

nucleus78.7579 -
N' TEF2pr-mCherry in SD
nucleus93.3684 -
N' NATIVEpr-GFP in SD

nucleus35.6286 -
N' TEF2pr-VC and Cyto-VN in SD
below threshold25.4175 -
C’ GFP library in SD+DTT

cytosol19.680.88No -
C’ GFP library in SD+H2O2

cytosol231.03No -
C’ GFP library in Starvation Media

cytosol35.711.61No -
C’ GFP library on the background of Pup2-DaMP

cytosol -
C’ GFP library on the background of CCT mutant

cytosol20.91060.942754No
